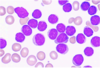

Hæmatologi Flashcards
(425 cards)
En patient er indlagt på geriatrisk afdeling til rehabilitering efter operation for hoftefraktur. Hun havde både før indlæggelsen og efter operationen normal hæmoglobinkoncentration (HgB). Hun har været en del sengeliggende efter operationen og fået heparin som tromboseprofylakse og på grund af smerter er hun startet behandling med Ibuprofen og paracetamol.
Blodprøver viser nu:
- HgB 4,8 mmol/l
- MCV = 70 fl
- Trombocyttal = 550 mia/l
- Leukocyttal = 6,3 mia/l med normal differentialtælling
- CRP = 4 mg/l.
Hvad er den mest sandsynlige forklaring på blodprøverne?
- a. Der er med stor sandsynlighed tale om anæmi ved inflammation (anæmi ved kronisk sygdom) som er blevet mikrocytær pga det langvarige forløb
- b. Der er med stor sandsynlighed tale om Heparininduceret trombocytopeni, der har udløst blødning og herved anæmi
- c. Der er med stor sandsynlighed tale om kostbetinget jernmangelanæmi, som følge af hendes lange hospitalsforløb og insufficiente fødeindtag
- d. Der med stor sandsynlighed tale om blødning fra ventrikelulcus som er opstået følge af hendes behandling og som medfører jernmangelanæmi
- e. Der er med stor sandsynlighed tale om folinsyremangel, da hun har været småtspisende efter operationen
*d. Der med stor sandsynlighed tale om blødning fra ventrikelulcus som er opstået følge af hendes behandling og som medfører jernmangelanæmi
Note: Patientens høje trombocyttal skyldes heparinbehandling. Ibuprofen og paracetamol kan give blødning, som medfører jernmangelanæmi (mikrocytær anæmi)
Hvilket udsagn om jernmangelanæmi er korrekt?
- a. Jernmangelanæmi er et symptom, hvor den tilgrundliggende årsag skal findes
- b. Ved jernmangelanæmi er middelcellevolumen normal (normocytær)
- c. Ved jernmangelanæmi er celledelingen i hæmatopoiesen kompromitteret
- d. Jernmangelanæmi forklarer 85% af alle tilfælde af anæmi
- e. Jernmangelanæmi er typisk for myelodysplastisk syndrom
*a. Jernmangelanæmi er et symptom, hvor den tilgrundliggende årsag skal findes
- Noter:*
- a. korrekt*
- b. jernmangelanæmi er en mikrocytær anæmi*
- c. modningen er komprimitteret*
- d. den forklarer 50% (20-50%)*
- e. jernmangelanæmi er en mikrocytær anæmi, mens der ved MDS ses makrocytær anæmi*
Hvilket udsagn om primær immuntrombocytopeni (ITP) er korrekt?
- a. ITP er en autoimmun sygdom som udelukkende ses hos børn
- b. ITP er en autoimmun sygdom, hvor trombocytopenien skyldes forkortet trombocytlevetid
- c. ITP er en autoimmun sygdom, hvor diagnosen stilles ved måling af trombocytantistoffer
- d. ITP er en autoimmun sygdom, hvor diagnosen stilles ved knoglemarvsbiopsi
- e. ITP er en autoimmun sygdom, hvor trombocytopenien skyldes mikrotrombosering
*b. ITP er en autoimmun sygdom, hvor trombocytopenien skyldes forkortet trombocytlevetid
- Note: ITP er en autoimmun sygdom, hvor autoanitsoffer mod trombocytter medfører forkortet trombocytlevetid.*
- a. Sygdommen ses både hos børn og voksne, men der er forskel på sygdommen hos børn og voksne.*
- b. korrekt*
- c. ITP diagnosen er en eksklussionsdiagnose*
- d. ITP diagnosen er en eksklussionsdiagnose*
- e. dette udsagn gælder for TTP*
En 69-årig kvinde klager over tiltagende rygsmerter gennem en måned. Ved objektiv undersøgelse er der ømhed sv. t. lænderyggen, men ingen kyfose eller skoliose. Rtg. af columna viser partiel kollaps af Th11 samt flere 0,5 til 1 cm store lytiske forandringer i torakale og lumbale vertebrae. Der laves en knoglemarvsundersøgelse, og en udstrygning af marvaspiratet ses nedenfor.
Hvilket af de følgende laboratoriefund vil mest sandsynligt være til stede hos denne patient?
- a. M-komponent i serum
- b. t(9;22) i karyotype fra marv
- c. Høj leukocyt alkalisk fosfatase (LAP) score
- d. Nedsat calcium-ion i serum
- e. Trombocyttal på 750 109/l

*a. M-komponent i serum
Note: mistanke om myelomatose, hvor der ses M-komponent (klonale plasmaceller) i blodet. Her er knoglesygdom herunder lytiske forandringer typisk symptom.
En 39-årig fik pludselig opstået hovedpine. Ved objektiv undersøgelse findes ingen neurologiske udfaldssymptomer eller organomegali. En fæcesprøve er positiv for okkult blod. Der fremkommer områder med kutan purpura på ekstremiteterne. Blodprøver viser Hb på 5,9 mmol/l, hæmatokrit på 29 %, trombocyttal på 29 x 109/l (150-450), og leukocyttal på 75 x 109/l. Udstrygning af perifert blod ser ud som vist nedenfor, og der er desuden schistocytter. Plasma D dimer, trombintid og APTT er alle forhøjede.
Hvilken af følgende karyotype-forandringer vil en cytogenetisk undersøgelse af patientens knoglemarv sandsynligvis vise?
- a. t(8;21)
- b. t(9;22)
- c. t(14;18)
- d. t(15;17)
- e. t(8;14)

*d. t(15;17)
Note: t(15;17) giver akut promyelocytleukæmi (APL), som er en subtype af AML. Klassisk er:
- kutan purpura
- anæmi
- epistaxis
- forhøjet APTT
- leukocytal >10 mia/l
- svær trombocytopeni
- forhøjet D-dimer
- forhøjet APTT*
- Når man har et trombocyttal på under 30-40 mil/L så skal man mistænke APL. Dette lave tal giver selvfølgelig anledning til kurtan purpura og epistaxis.*
- Schistocytter har vi lært er der ved TTP. De er der åbenbart også ved APL.*
En 60-årig kvinde har haft hovedpine og svimmelhed gennem de seneste 5 uger. Hun har taget medicin for sure opstød (cimetidin) og mavesår (omeprazol). Ved objektiv undersøgelse findes hun afebril og normotensiv, og hendes ansigt har et rødligt-cyanotisk skær. Der er let splenomegali men ikke andre abnorme fund.
Blodprøver viser
- Hb på 13,1 mmol/l
- Hæmatokrit 65%
- Trombocytter 400 x 109/l.
- Leukocyttallet er 30 x 109/l med
- 85 % neutrofile granulocytter
- 10 % lymfocytter
- 5 % monocytter.
- Udstrygning af perifert blod viser abnormt store trombocytter.
- Serum-EPO er umåleligt lavt, men S-ferritin er normal.
Hvilket af det følgende er mest karakteristisk for denne patients sygdoms naturhistorie?
- a. Død som følge af transformation af sygdommen til akut B-lymfoblastisk leukæmi
- b. Udvikling af marvfibrose med ekstensiv ekstramedullær hæmatopoiese i milten
- c. Spontane remissioner og recidiver uden behandling
- d. Gradvis stigning i monoklonal serum immunglobulin
- e. Udvikling af ventrikellymfom
*b. Udvikling af marvfibrose med ekstensiv ekstramedullær hæmatopoiese i milten
Note: Mistænker PV, som kan udvikle sig til marvsfibrose med ekstramedullær hæmotopoiese i milten.
Tegn i anamnesen på PV:
- Forhøjet hæmoglobin og hæmatokrit
- Rødligt cyanotisk skær i ansigtet–>hypertension som medfører rødblussende kinder
- Typisk normalt trombocyttal
- Typisk forhøjet leucocyttal
Du skal informere om en 78-årig mand som netop har fået konstateret diffust storcellet B-celle lymfom st. 4B og er kendt med hypertension, adipositas, type 2 diabetes og kronisk obstruktiv lungesygdom om behandling og prognose.
Hvilket af nedenstående udsagn indrammer bedst den optimale information.
- a. Der er tale om en potentielt kurabel sygdom hvis den behandles med intensiv immun- kemoterapi
- b. Der er tale om en inkurabel sygdom hvor behandlingen alene har sygdomskontrollerende sigte
- c. Der er tale om en potentielt kurabel sygdom hvis den behandles med immun-kemoterapi, men der er betydelig risiko for komplikationer pga. co-morbiditet
- d. Der er tale om en kurabel sygdom hvis den behandles med en kombination af kemoterapi og strålebehandling
- e. Sygdommen er så avanceret at kun palliativ behandling er mulig
*c. Der er tale om en potentielt kurabel sygdom hvis den behandles med immun-kemoterapi, men der er betydelig risiko for komplikationer pga. co-morbiditet
Hvilken af følgende arvelige tilstande er forbundet med øget risiko for venøs tromboemboli?
- a. Faktor V Amsterdam
- b. Mangel på von Willebrand faktor
- c. Protein S-mangel
- d. Faktor VIII-mangel
- e. Tilstedeværelse af fosfolipid antistoffer
*c. Protein S-mangel
- Note:*
- a. Faktor V Amsterdam er forbundet med øget blødning.*
- b. Mangel på von Willebrand er forbundet med da de indgår i trombocytaggregering.*
- c. Korrekt. Protein-S er en co-factor til Protein C. Pritein C nedbryder/inaktiverer factor V*
- d. Mangel af koagulationsfaktor–>blødning. VIII ses manglende hos blødersygdomme bl.a.*
- e. Fosfolipid antistoffer er forbundet med øget risiko for båd evenøse og arterielle tromber, MEN det er ikke en arvelig tilstand.*
Hvad er sandt vedrørende mangel på von Willebrand faktor:
- a. Mistænkes ved forlænget INR
- b. Giver altid forlænget APTT
- c. Medfører kun milde blødningssymptomer
- d. Er hyppigt forekommende (findes hos ca. 1% af befolkningen)
- e. Primært symptomgivende hos mænd
*d. Er hyppigt forekommende (findes hos ca. 1% af befolkningen)
- Note:*
- a. Forkert. INR fortælle rnoget om koagulationsfaktor II, VII og X.*
- b. Forkert.*
- c. Forkert. Det kan give milde, men også kraftige blødninger.*
- d. Korrekt*
- e. Forkert. Både mænd og kvinder kan have sygdommen og kan have symptomer. Dog opdager kvinder det ofte hurtigere via kraftige menstruationsblødninger.*
Lavmaligne lymfomer, såsom follikulært lymfom kan undergå histologisk transformation (HT) til diffust storcellet B-lymfom (DLBCL).
Hvilket af nedenstående udsagn er IKKE gældende for HT?
- a. Ofte ses markant stigende LDH
- b. Ofte ses tilkomst af B-symptomer
- c. Risikoen er ca. 10 % pr. år
- d. Ofte ses hurtig tilvækst af lymfomer
- e. Risikoen er ca. 1-3 % pr. år
*c. Risikoen er ca. 10 % pr. år
En 23-årig kvinde har haft subfebrilia 37,5-38,5 gennem 6 uger. Hun har tillige tabt sig 5 kg i samme periode. Hun sveder om natten. Objektivt finder du en fast hævelse i højre halsrod, og mistanke om forstørrede lymfeknuder i højre aksil. Spredt på crurae, lår og overarme samt i begge flanker ses kradsningslæsioner.
Biokemisk ses som abnorme fund:
- LDH på 265 U/l
- Hæmoglobin 7,1 mmol/l
- Leukocytter på 15,4 mia/l
- Trombocytter 560 mia/l.
Hvilken af følgende hæmatologiske diagnoser er mest sandsynlig
- a. Myeloidt sarkom
- b. Follikulært lymfom
- c. Kronisk myeloid leukæmi
- d. Mantlecellelymfom
- e. Hodgkin lymfom
*e. Hodgkin lymfom
Note: Patienten har B-symptomer og hudkløe, hvilket er klasiske symptomer for Hodgkin. Derudover er biokemien:
- Lymfopeni
- Leucocytose
- Trombocytose
- Forhøjet CRP
- Normal eller let forhøjet LDL
37-årig kvinde kommer til almen praksis med
- Hæmoglobin 7,8 mmol/L
- Leukocytter 5,6 mia/L
- Thrombocytter 1260 mia/L
- CRP<5,0.
Hvilken diagnose er mest sandsynlig?
- a. Essentiel thrombocytose
- b. CML
- c. Reaktiv trombocytose pga. infektion
- d. Polycytemia vera
- e. APL
*a. Essentiel thrombocytose
Note: ET er karakteriseret ved abnormt højt trombocyttal og denne pt. vil være i “højrisiko”-gruppen
85-årig mand Kommer til egen læge, der tager blodprøver. Blodprøverne viser
- Hæmoglobin 5,0 mmol/l
- Leukocytter 2,1 med 0,9 mia/l neutrofilocytter
- Thrombocytter 50 mia/l
- MCV 106 fl.
- Cobalamin, haptoglobin og folat i normalområdet.
Hvilken af følgende diagnose er mest sandsynlig?
- a. CML
- b. CLL
- c. ITP
- d. TTP
- e. MDS
*e. MDS
- Note: MDS er svigt af knoglemarven, hvilket medfører mangel på celler. Ved MDS (og ALL) ses makrocytær anæmi.*
- CML: Nej der vil være trombocytose og leucocytose ved CML*
- CLL: samme som ovenstpende*
- ITP: ITP er en eksklusionsdiagnose og vi har ikke udelukket MDS*
- TTP: Associeret med hæmolytisk anæmi, men haptoglobin er normal–>formentlig ingen hæmolyse.*
- MDS: ja den passer bedst*
Hvilken cytogenetisk forandring passer bedst på CML
- a. t(8;21)
- b. t(15;17)
- c. t(9;22)
- d. Inv(16)
- e. t(9;11)
*c. t(9;22)
Hvilket udsagn passer til definitionen på neutropen feber?
- a. Temperatur > 38,50 og neutrofilocytter < 0,5 mia/L
- b. Temperatur > 38,50 og neutrofilocytter = 1,0 mia/L
- c. Temperatur = 380 ved én måling og neutrofilocytter < 0,5 mia/L
- d. Temperatur = 380 igennem 4 timer og neutrofilocytter = 1,0 mia/L
- e. Alle ovenstående
*a. Temperatur > 38,50 og neutrofilocytter < 0,5 mia/L
- Note:*
- a. Korrekt*
- b. Forkert - havde været rigtig hvis der stod, at neutrofile granulocytter var faldende*
- c. Forkert - 38 grader ved 3 målinger over 3 timer*
- d. Forkert - igen havde det været rigtigt hvis der nu stod at neutrofile var faldende*
- e. nej*
Hvilken af følgende tilstande er IKKE målet ved allogen knoglemarvstransplantation hos patienter med aplastisk anæmi?
- a. Ny erytropoiese
- b. Ny trombopoiese
- c. Ny granulopoiese
- d. Ny lymfopoiese
- e. Graft versus tumor effekt (GVL)
*e. Graft versus tumor effekt (GVL)
75-årig mand henvender sig til egen læge på grund af træthed og tilbagevendende infektioner gennem de sidste 6 måneder. Der har været beskedent vægttab. Der har ikke været synlige blødninger. Findes upåvirket med enkelte ca 2 cm store lymfeknuder på begge sider af hals og milten føles let forstørret ved dyb inspiration.
De første blodprøver viser:
- Hgb 6,8 mmol/l (8-11)
- Ery-MCV 88 fl (80-100)
- Leukocytter 133 mial/l (4-10 mia/l)
- Thrombocytter 170 mia/l (150-400)
- CRP 8 mg/l (<10).
Hvilken af følgende diagnoser er mest sandsynlig?
- a. Ideopatisk myelofibrose
- b. Akut myeloid leukæmi
- c. Hodgkin lymfom
- d. Kronisk lymfocytær leukæmi
- e. Waldenstrøms makroglobulinæmi
*d. Kronisk lymfocytær leukæmi
Note: klassiske kliniske fund/symptomer ved CLL:
- B-symptomer:
- vægttab
- feber
- nattesvted
- Træthed
- Infektion
- Blødning
- Anæmi
- Lymfeknudesvulst
- Splenomegali
Bider mærke i at der er anæmi samt leucocytose. CLL kan sagtens have normale parametre ud over leucocyttallet
Hvilket af følgende symptomer, parakliniske fund eller komplikationer er mindst forventelig hos nydiagnosticeret patient med myelomatose, som endnu ikke er startet behandling
- a. Normocytær anæmi
- b. Patologisk fraktur af rørknogle
- c. Proteinuri og forhøjet kreatinin på 300 umol/l
- d. Hyperkalkæmi med serum Ca-ion på 1,98 mmol/l
- e. Moderat splenomegali
*e. Moderat splenomegali
- Note: Myelomatose er en M-komponent sygdom, der medfører en række karakteristika.*
- M-komponent syntesen medfører:*
- hyperviskositet
- nyresvigt–>proteinuri
- amyloidose
- neuropai
Knoglesygdom:
- smerter
- brud
- bøjning
- hyperkalkæmi
Knoglemarvssvigt:
- anæmi
- leucocytopeni
- trombocytopeni
- infektion
- immunparese
- evt. tværsnitssyndrom
MGUS står for ”monoklonal gammopathi af ukendt betydning”, men er dog reelt ikke uden velbeskrevet betydning.
Hvilket af følgende udsagn er IKKE korrekt.
- a. MGUS af IgA og IgG subtype er forbundet med øget risiko for udvikling af myelomatose
- b. MGUS er forbundet med øget risiko for udvikling arteriosclerose og myokardie infarkt
- c. MGUS af let-kæde kappa eller let-kæde lambda type medfører øget risiko for udvikling af amyloidose
- d. MGUS af IgM type medfører øget risiko for udvikling af Waldenstrøms makroglobulinæmi
- e. MGUS er IgM type medfører større risiko for udvikling af perifer polyneuropathi end der ses ved MGUS af IgA eller IgG type
*b. MGUS er forbundet med øget risiko for udvikling arteriosclerose og myokardie infarkt
63-årig kvinde med akut myeloid leukæmi (AML) i komplet remission efter 4 serier intensiv kemoterapi, indstilles til allogen knoglemarvstransplantation. Hvilken donortype er første valg?
a. Ubeslægtet donor med 10/10 allel vævstypeforligelighed
b. Ubeslægtet donor med 9/10 allel vævstypeforligelighed
c. Navlesnors donor
d. Beslægtet heterozygot donor med 10/10 allel vævstypeforligelighed
e. Beslægtet homozygot donor med 10/10 allel vævstype forligelighed
d. Beslægtet heterozygot donor med 10/10 allel vævstypeforligelighed
52-årig kvinde indlægges via egen læge obs. Hæmatologisk sygdom. Blodprøverne ved ankomst viser thrombocytter på 90 mia/L, hæmoglobin 5,5, leukocytter 2,0 med 0,89 MIA/L neutrofilocytter, MCV 105.
Hvilken sygdom kunne man mistænke?
a. Myelomatose
b. jern-mangel anæmi
c. Morbus Waldenstrøm
d. Seglcelle anæmi
e. Myelodysplanstisk syndrom
e. Myelodysplanstisk syndrom
* Note: MDS er svigt af knoglemarven og dermed lavt antal blodceller, hvilket er tilfældet her. Karakteristisk er makrocytær anæmi.*
En 55-årig mand indlægges på akut med leukocytter på 150. Er afebril, konfus og rodende og klager over synspåvirkning, CRP<5. Hvilken årsag er mest sandsynlig
a. Kataract
b. Nethindsløsning
c. Leukostase
d. Parkinsonisme
e. Meningitis
c. Leukostase
* Note: Hvis de hvide blodlegemer ved akut leukæmi er meget forhøjede, kan man i nogle tilfælde udvikle det fænomen, der kaldes leukostase, hvor man får udtalt åndedrætsbesvær og nogle gange også forvirret sindstilstand*
53-årig mand indlægges med talrige hæmatomer og epistaxis. blodprøverne viser Hgb 6,2 leukocytter 1,2 Thrombocytter 50 samt let nedsat KFNT 0,55, let forlænget APTT 38 og d-dimer>20. Hvilken leukæmi bør man mistænke?
a. ALL
b. APL
c. CLL
d. CML
e. PLL
b. APL
Hvilket af følgende udsagn passer på diagnosen polycytemia vera?
a. JAK-2 positiv og supprimeret s-EPO
b. ineffektiv hæmatopoiese
c. Philadelphia kromosom positiv
d. Cholecystolithiasis
e. Asplenisme
a. JAK-2 positiv og supprimeret s-EPO
- Noter:*
- a. Korrekt. “Plasma erytropoietin (EPO) er typisk nedsat, og stort set alle patienter har JAK2V617F-mutationen”*
- b. Polycytæmi vera er en myeloproliferativ neoplasi, som øger de tre celleinjer, og der vil altså være flere celler, hvilket ikke er foreneligt med ineffektiv hæmatopoiese.*
- c. Det er t(9;22) og det giver CML*
- d. det er hæmolytisk anæmi (heriditær sferocytose) som tit har det*
- e. ??*